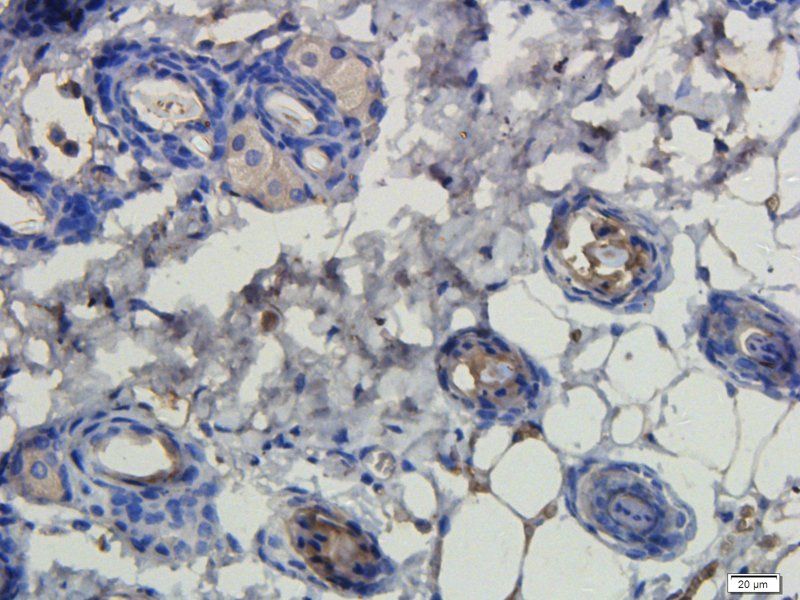
产品细节图片1
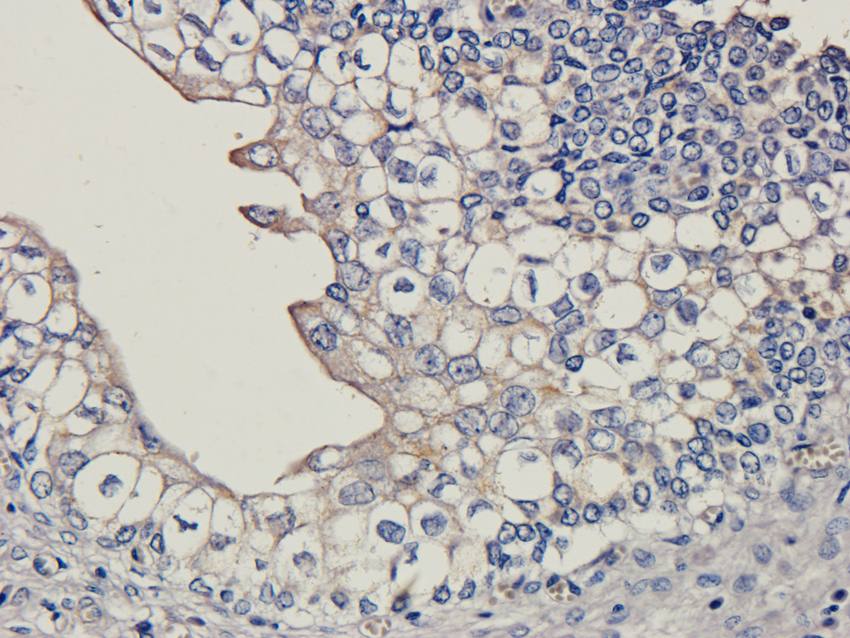
产品细节图片5
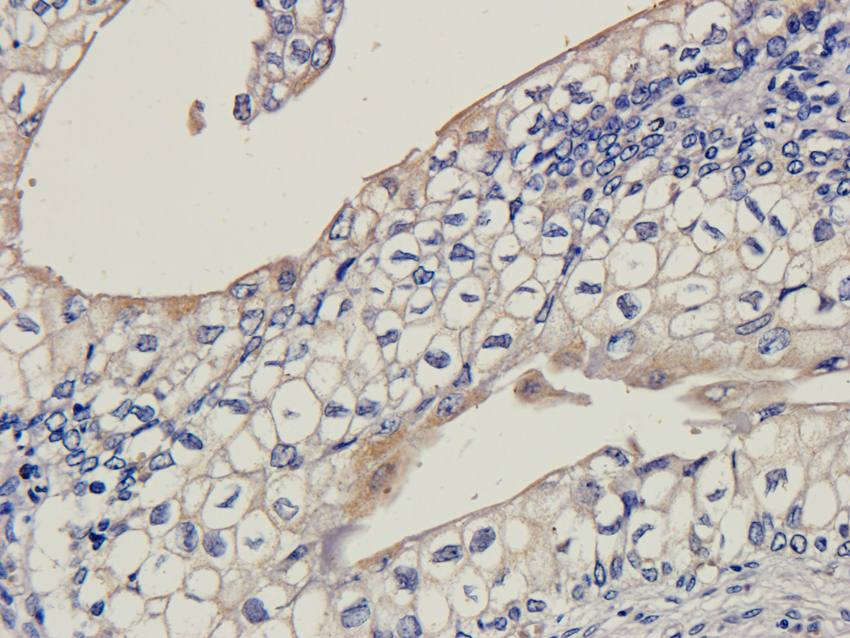
产品细节图片7

相关产品推荐更多 >
万千商家帮你免费找货
0 人在求购买到急需产品
- 详细信息
- 文献和实验
- 技术资料
- 抗体名:
LHCGR antibody抗体
- 抗体英文名:
LHCGR antibody
- 靶点:
LHCGR
- 浓度:
- 100 μg (in 200 μl): 0.5 mg/ml- 200 μg (in 400 μl): 0.5 mg/ml
- 应用范围:
ICC, IF, IHC-P, WB
- 宿主:
Rabbit
- 适应物种:
Human, Mouse, Porcine, Rat
- 保质期:
6-12个月
- 抗原来源:
详询
- 目录编号:
orb13542
- 级别:
科研级
- 库存:
88
- 供应商:
biorbyt
- 标记物:
Unconjugated
- 克隆性:
Polyclonal
- 形态:
10 mM PBS, 0.02% sodium azide
- 亚型:
IgG
- 免疫原:
KLH conjugated synthetic peptide derived from human LHCGR. Please contact us for the exact immunogen sequence. The peptide is available as orb12912.
- 规格:
100 ug
别名:anti-Gonadotropin receptor antibody, anti-GTHR-II antibody, anti-HHG antibody, anti-LCGR antibody, anti-LGR2 antibody, anti-LH-R antibody, anti-LH/CG R antibody, anti-LH/CG-R antibody, anti-LH/CGR antibody, anti-LHCGR antibody, anti-LHR antibody, anti-LHRHR antibody, anti-LSH R antibody, anti-LSH-R antibody, anti-Luteinizing hormone receptor antibody, anti-Luteinizing hormone/choriogonadotropin receptor antibody, anti-ULG5 antibody
免疫原:KLH conjugated synthetic peptide derived from human LHCGR. Please contact us for the exact 免疫原 sequence. The peptide is available as orb12912.
分子量:78 kDa
应用稀释比例:IF/ICC: 1:50-400, WB: 1:200-1000, IHC-P: 1:50-400
纯度:Polyclonal antibodies are purified by peptide affinity chromatography
保存说明:Maintain refrigerated at 2-8°C for up to 2 weeks. For long term storage store at -20°C in small aliquots to prevent freeze-thaw cycles.
NCBI:11, 013582, 21, 038610
Entrez:16867
UniProt ID:P30730, P16235
Note:For research use only.

风险提示:丁香通仅作为第三方平台,为商家信息发布提供平台空间。用户咨询产品时请注意保护个人信息及财产安全,合理判断,谨慎选购商品,商家和用户对交易行为负责。对于医疗器械类产品,请先查证核实企业经营资质和医疗器械产品注册证情况。
 文献和实验
文献和实验Cell Rep Med:中山大学项鹏 / 邓春华团队联合开发基因疗法恢复小鼠睾酮分泌与生育能力
(Adeno-associated virus,AAV)具有组织细胞靶向性、免疫原性低以及非整合性等多种优势,在基因治疗中发挥重要作用。但 AAV 介导的基因疗法治疗 LCF 的可行性、安全性及有效性如何,尚未见报道。 2022 年 10 月 20 日,中山大学中山医学院项鹏团队联合中山大学附属第一医院邓春华团队,在 Cell Reports Medicine 发表了题为 AAV-mediated gene therapy produces fertile offspring in the Lhcgr
三句话读懂一篇 CNS:神奇细菌可降解尼古丁,减少吸烟危害;瘦的女性,心脏功能反而更好?
Medicine:发现腺相关病毒介导基因治疗可恢复小鼠睾酮分泌与生育能力 不孕不育已成为困扰相当一部分人的健康问题。 2022 年 10 月 20 日,中山大学项鹏课题组与中山大学附属第一医院邓春华团队合作在 Cell Reports Medicine 杂志发表研究论文 AAV-mediated gene therapy produces fertile offspring in the Lhcgr-deficient mouse model of Leydig cell failure。 该研究
by a two- or three-step procedure. The method can insert any fragment into small or large episomes, without the need of an antibiotic selection gene. We have humanized the mouse luteinizing hormone receptor gene (Lhcgr ) by inserting a ~55 kb fragment from a BAC clone
 技术资料
技术资料暂无技术资料 索取技术资料











